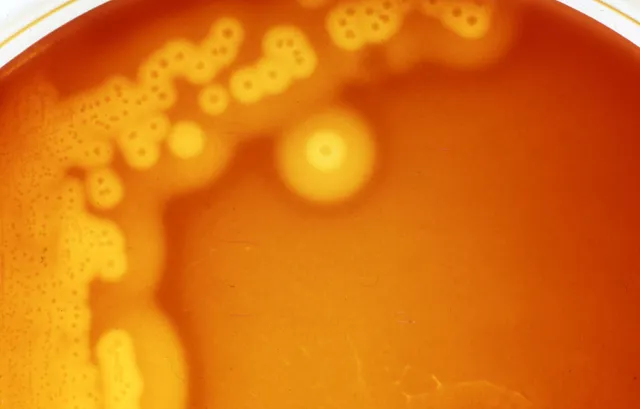
Target hemolysis (Double zone hemolysis) - Target hemolysis (Double zone hemolysis)Image source: UPEI University
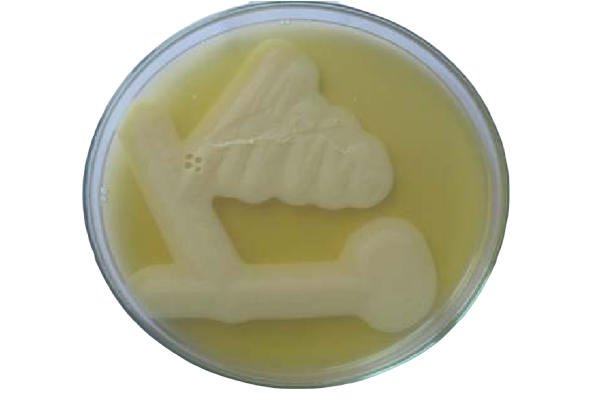
Lecithinase activity of C. perfringens in Egg Yolk Agar - Lecithinase activity ofC. perfringens in Egg Yolk Agar (Image source: Palaniappan Srinivasan)
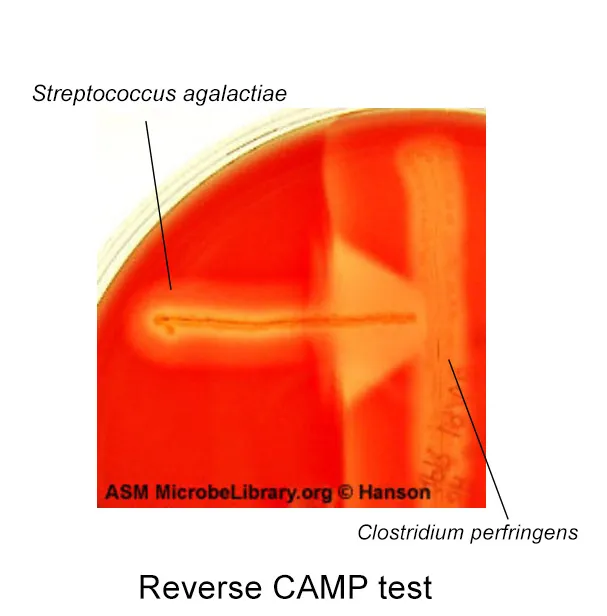
Reverese CAMP test

Clostridium perfringens is a gram-positive, anaerobic, endospore-forming bacilli, often appear as boxcar shaped. It is mainly responsible for myonecrosis (gas gangrene), food poisoning, and gangrenous cholecystitis.

Properties
- **Gram staining:**Gram-variable straight rods with blunt ends occurring singly or in pairs; spores seldom seen but if present is large and central to subterminal, oval, and swell cell; large boxcar shape.
- It is capsulated, non-motile, gram-positive bacillus.
- It bears sub-terminal bulging spores but does not produce spores in tissues or in culture media (especially the gas gangrene strains).
- It is invasive as well as toxigenic.
Transmission
Clostridium perfringensis a saprophyte in soil and also a commensal in the large intestine of human beings and animals. People get infected when the spores contaminate wounds from trauma.
Clinical manifestations
C. perfringensinfections are mostly polymicrobial involving other clostridia species. Various manifestations include:
Clostridial Wound Infections
- Simple wound contamination: It involves the wound surface contamination, without invasion of underlying tissue, as occurs in the absence of devitalized tissue.
- Crepitant cellulitis (anaerobic cellulitis) is seen in diabetic patients. It involves the fascial plane with minimal toxin release, without muscle invasion.
- Anaerobic myositis (gas gangrene): Clostridial myonecrosis (gas gangrene) is a serious infection that involves rapid invasion and liquefactive necrosis of muscle with the gas formation and clinical signs of toxicity. Pockets of gas are seen within the muscles and subcutaneous tissue and as the liquefaction of muscle continues a thin, blackish fluid exudes from the skin. The other clostridia most often involved in gas gangrene are C. sordelli, C. septicum, and occasionally C. histolyticum.
Clostridial Enteric infection
- Food poisoning:
Type A toxin-producing C. perfringens are a major cause of food-borne disease. C. perfringens food poisoning results from the consumption of raw or improperly contaminated meat and other food products containing a large number of (about 10^8 viable) organisms. Spores being heat resistant survive and germinate later when the food is cooled. Enterotoxin acts by forming pores in the intestinal mucosal membrane.
- Necrotizing enteritis (enteritis necroticans, NEC) is a life-threatening infection caused by Clostridium perfringens type C and type A and characterized by ischemic necrosis of the jejunum and gas in the tissue plane. The disease was called “Darmbrand” (meaning “fire bowels”) in Germany and “Pig bel” in Papua New Guinea.
Other Clostridial infections are puerperal infections, anaerobic pleuropulmonary infections, and clostridial bacteremia. In rare cases, C. perfringens also causes meningitis, meningoencephalitis, and subdural empyema.
Laboratory diagnosis
Based on the clinical diagnosis of gas gangrene, treatment should be started as early as possible. Laboratory diagnosis has a role only for (1) confirmation of the clinical diagnosis, (2) species identification.
Laboratories can diagnoseC. perfringensfood poisoning by detecting the bacterial toxin in feces using enzyme immunoassay or by quantitative anaerobic cultures. Serotyping of the isolates is done to determine if the same serotype ofC. perfringensis present in the epidemiologically implicated outbreaks.
Specimen
- Ideal specimens in the case of gas gangrene are necrotic tissues, muscle fragments, and exudates from deeper part of the wound where the infection appears to be more active. Other specimens depending on the type of infections include suspected food (to investigate food poisoning), feces, etc.
- Blood culture may be positive for C. perfringensandC. septicum. However, C. perfringens bacteremia can occur even in the absence of gas gangrene
- Swabs rubbed over the wound surface or soaked in exudates are not satisfactory.
- Specimens should be put into Robertson’s cooked meat broth and transported immediately to the laboratory.
Direct Microscopy
Gram-stained smears of aspirated material from myonecrosis reveal a necrotic background with a lack of inflammatory cells and presence of gram-positive bacilli with a morphology resembling C. perfringensor other clostridia. Gram stained films provide clues about the species of clostridia present.

- Thick, stubby, boxcar-shaped, gram-positive bacilli without spore are suggestive of *C. perfringens.*The cells of C. perfringensare usually 0.8 to 1.5 ÎĽm in diameter Ă— 2 to 4 ÎĽm long and have blunt ends. They are often described as boxcar-shaped.
- Spore bearing gram-positive bacilli suggest other clostridia species
Citron bodies (boat or leaf-shaped) pleomorphic irregularly stained bacilli with spores suggest C.septicum. Large rods with oval sub-terminal spores- suggest C. novyi
Culture
Culture plates should be incubated anaerobically at 37oC for 2 days. Clostridium perfringens do not produce spores in media routinely used in the clinical laboratory.
**Blood agar:**After overnight incubation on blood agar, colonies are usually 1 to 3 mm in diameter, but may reach a diameter of 4 to 15 mm after prolonged incubation. Colonies are usually flat, somewhat rhizoid, and raised centrally. Some colonies tend to spread, but they do not swarm.
Target hemolysis (double zone hemolysis)
On anaerobic blood agar, C. perfringens produces irregular colonies with an inner narrow zone of complete hemolysis (due to theta toxin), surrounded by a much wider zone of incomplete hemolysis (due to the alpha-toxin).
Nagler’s reaction
*****C. perfringens*produces an opalescence surrounding the streak line on egg yolk agar (EYA) or media containing 20% human serum due to lecithinase activity of alpha toxin. Opalescence can be inhibited by incorporating anti-alpha toxin to the medium. The test is also positive for other alpha toxin producing Clostridium; C. bifermentans, C. barattiand C. sordellii.
Reverse CAMP test
Suspected C. perfringens isolateis streaked over the center of anaerobe blood agar plate and Streptococcus agalactiae is streaked perpendicular to it. Presence of arrowhead of synergistic hemolysis with the tip of the arrow pointing from the Streptococcus toward the C. perfringens, is a positive reverse CAMP test.
Heat tolerance
C. perfringens can grow when Robertson’s cooked meat (RCM) broth is incubated at 45°C for 4-6 hours. This differentiates it from other organisms in the specimen.
Litmus milk test
In litmus milk, C. perfringensproduces “stormy clot reaction” due to proteolysis of milk agar and fermentation of lactose producing acid and vigorous gas.

Other properties ofClostridium perfringens
- Non-motile
- Catalase negative
- No growth on chocolate agar in 5% CO2
References and further readings
- Tille, P. (2017). Bailey & Scott’s Diagnostic Microbiology (14 edition). Mosby.
- Procop, G. W., & Koneman, E. W. (2016). Koneman’s Color Atlas and Textbook of Diagnostic Microbiology(Seventh, International edition). Lippincott Williams and Wilkins.